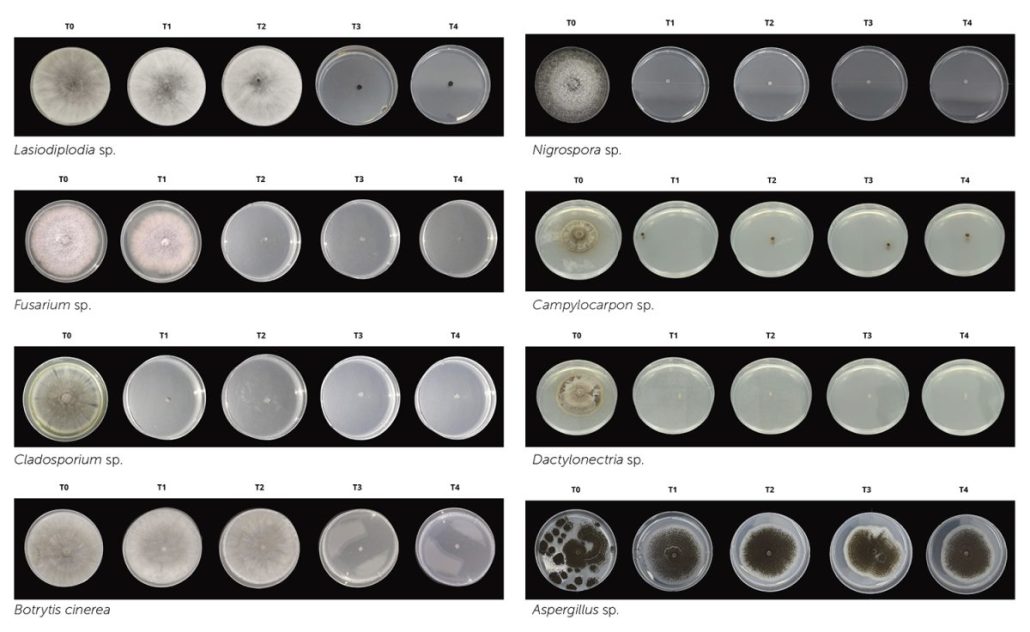

Protege tus cultivos antes y después de cosecha con PERIMAX®
Su acción rápida y potente elimina bacterias, hongos y virus; destaca por su seguridad, ya que no deja residuos tóxicos, y por su eficacia en superficies porosas y no porosas.

POR SEBASTIAN IGLESIAS OSORES JEFE DE INVESTIGACIÓN, REGISTROS Y DESARROLLO.
FÁTIMA COLOMA DESARROLLISTA TÉCNICO.
LUIS ALVAREZ BERNAOLA, ASESOR FITOPATÓLOGO.
Perimax® es un desinfectante de amplio espectro formulado con ácido peracético y peróxido de hidrogeno, diseñado para la sanitización industrial en la industria alimentaria, etc. Su acción rápida y potente elimina bacterias, hongos y virus; destaca por su seguridad, ya que no deja residuos tóxicos, y por su eficacia en superficies porosas y no porosas. Perimax® es la solución confiable para desinfección pre y post cosecha, garantizando cultivos sanos y libres de patógenos.
Se realizó un ensayo de inmersión para evaluar el efecto inhibitorio del ácido peracético utilizando cinco tratamientos: control, agua destilada estéril (T0: 0 μL/100 mL) y cuatro concentraciones crecientes del desinfectante (T1: 1.25 μL/100 mL, T2: 2.50 μL/100 mL, T3: 3.75 μL/100 mL y T4: 5.00 μL/100 mL), con cuatro repeticiones por tratamiento. Para cada réplica, se prepararon discos de micelio del hongo objetivo que se sumergieron durante 1 minuto en las respectivas diluciones, transfiriéndose posteriormente a placas con agar PDA + antibiótico para su incubación. El crecimiento micelial se cuantificó midiendo el diámetro de las colonias (mm). El crecimiento micelial de cada tratamiento fue monitoreado y cuantificado comparándolo con el control (T0), midiendo el diámetro de las colonias hasta que alcanzaron el borde de la placa Petri (cobertura completa), para determinar la eficacia inhibitoria.
Los resultados estadísticos demostraron que Perimax® tuvo un efecto significativo en la inhibición de los microorganismos evaluados (tabla 1). El análisis ANOVA reveló interacciones altamente significativas entre el tipo de microorganismo y la dosis aplicada (p<0.001), con diferencias marcadas en la eficacia según la concentración. Las pruebas de Kruskal-Wallis confirmaron que todas las dosis (1.25, 2.5, 3.75 y 5.0 mL/L) redujeron significativamente el crecimiento de los patógenos (p<0.000 para Botrytis cinerea, Fusarium sp., y otros), excepto para Aspergillus sp., donde el ANOVA no mostró diferencias significativas entre dosis (p=0.688). Los análisis post-hoc con letras de Duncan destacaron que, a mayor dosis, mayor eficacia, agrupando las dosis altas (3.75 y 5.0 mL/L) como las más efectivas.
Tabla 1. Efecto inhibitorio del ácido peracético (Perimax®) sobre el crecimiento micelial (mm) de
diferentes microorganismos en función de la dosis aplicada (mL/L).

N=16, Dosis (mL/L) se refiere a mililitros por litro (unidad de concentración), Media ± DE media más/menos
la desviación estándar, IC95% indica el intervalo de confianza del 95%.
En microorganismos como Lasiodiplodia sp., Botrytis cinerea y Fusarium sp., que son conocidos por su papel relevante en pudriciones post cosecha, se observó una inhibición significativa incluso a concentraciones intermedias. Por otro lado, Aspergillus sp. no mostró diferencias significativas entre las dosis, lo que podría atribuirse a una mayor tolerancia (Figura 1). Además, el hecho de que algunas especies como Nigrospora sp. y Cladosporium sp. respondieran significativamente a dosis más bajas indica, optimizando así la relación costo-beneficio y reduciendo el impacto ambiental.

Figura 1. Distribución del halo de inhibición por dosis y microorganismo.


Contactos:
Sebastian Iglesias Osores
Jefe de Investigación,
Registros y Desarrollo
sebastian.iglesias@clenvi.pe
Fatima Coloma
Desarrollista técnico
fatima.coloma@clenvi.pe









